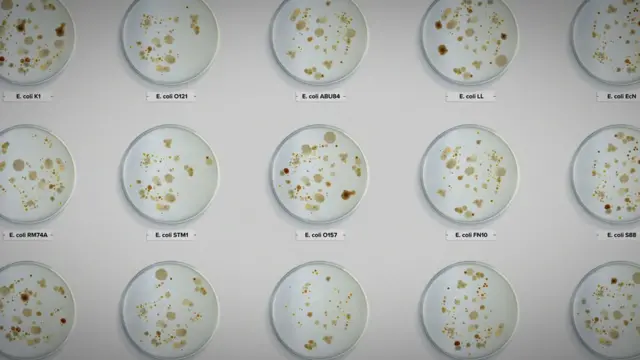
Dishes containing various types of E. coli bacteria

Netfliksov savetnik u seriji „Otrovan: Prljava istina o vašoj hrani“ poručuje nam šta da ne jedemo

Autor fotografije, Getty Images
- Autor, Mark Šej
- Funkcija, BBC svetski servis
- Objavljeno
Bil Marler je advokat za bezbednost hrane koji se poslednjih trideset godina bori za žrtve obolele od ešerihije koli, salmonele, listerije i drugih bolesti koje potiču iz hrane.
On se pojavljuje često u novom Netfliksovom dokumentarcu Otrovan: Prljava istina o vašoj hrani, koja je započela život kao knjiga o njegovom prvom velikom slučaju.
On je za BBC naveo koju hranu treba izbegavati ako želite da izbegnete da se razbolite.
Život je bio pred Stefani Ingberg - sedamnesteogodišnjom Amerikankom iz Sent Luisa koja je za prolećni raspust stigla sa roditeljima u odmaralište u Dominikanskoj Republici.
Mučio ju je stomak pre leta, ali nije se mnogo obazirala i čak se osećala bolje po dolasku.
Međutim, tokom čitave noći joj je bilo sve gore i završila je u bolnici.
Narednog jutra nije prepoznala majku, otkazali su joj bubrezi, otekao joj je mozak i dobila je epileptične napade.
Njeni roditelji su ugovorili hitno medicinsko prebacivanje nazad u SAD, gde je potvrđeno da je pretrpela tešku bakterijsku infekciju ešerihijom koli.
Njeno stanje se tokom noći pogoršalo, pala je u komu i pozvan je sveštenik da joj pročita oproštajnu molitvu.
Stefani je jedna od ključnih sagovornika u Netfliksovom dokumentarcu Otrovan: Prljava istina o vašoj hrani, koji se bavi time kako propusti u higijeni našeg lanca ishrane mogu istinski da dovedu do katastrofalnih posledica po potrošače.
Dok je sveštenik počinjao da izgovara molitvu, Stefanine oči su se otvorile.
Ona je preživela, ali ima doživotne posledice od susreta se ešerihijom koli.

Autor fotografije, Netflix
„Moram da uzimam lekove svaki dan da bih pokušala da pojačam filtere u svojim bubrezima", kaže ona u dokumentarcu.
„Postoji mogućnost da će morati da mi presade bubreg. Možda ću morati da budem na dijalizi do kraja života. Nikada ne želite tako nešto da čujete.
„Pojela sam salatu i sada imam dugoročne zdravstvene posledice od toga."
Stefani je jedna od 600 miliona ljudi koliko Svetska zdravstvena organizacija (SZO) procenjuje da se razboli svake godine od kontaminirane hrane.
Srećom, ona nije bila jedna od 420.000 koji i umru.
Obraćanje pažnje na to šta jedete može da vam spase život - tako da evo šta Bil Marler predlaže da izbegavate da biste ostali zdravi.
Nepasterizovano mleko i upakovani sokovi
Marlerova profesionalna iskustva navela su ga da se odrekne sirovih ili nepasterizovanih mlečnih proizvoda i nepasterizovanih sokova.
Rizik je ovde od iste bakterije ešerihije koli od koje se toliko razbolela Stefani.
„Nijedna prepostavljena prednost nepasterizovanog mleka prosto nije vredna tog rizika. Ljudi su zaboravili na bolesti koje su postojale u Devetnaestom veku", kaže Bil Marler, advokat i stručnjak za bezbednost hrane.
Sirove klice

Autor fotografije, Getty Images
A Marler ne jede ni sirove klice kao što su alfalfa, zeleni pasulj, detelina ili klice pasulja.
One se vezuju za neke od najvećih svetskih epidemija bolesti nastalih iz hrane.
Epidemija iz 2011. godine u Nemačkoj povezana sa semenom piskavice dovela je do toga da 900 ljudi doživi otkazivanje bubrega, a više od 50 njih umre.
„Semenje se kontaminira dok raste napolju. Kad ga unesete i stavite u lepu čistu vodu da proklija, to je savršen medijum za širenje bakterija", kaže Marler.
„Ne znam nikoga iz oblasti bezbednosti hrane ko jede sirove klice."
Nedovoljno pečeno meso
Što se tiče mlevenog ili sitno seckanog mesa, svaka bakterija koja se nalazila na površini mesa pomeša se sa njenom unutrašnjošću.
Zbog toga je važno da se hamburgeri dobro ispeku.
I ne treba vam mnogo bakterija da biste ozbiljno razboleli.
„Da vas ubije dovoljno je oko 50 bakterija ešerihije koli; 100.000 staje na glavu čiode. To nije nešto što možete da vidite, okusite ili namirišete. Jedini bezbedan način je da dobro ispečete hamburger."
On preporučuje da insistirate da se vaš burger ispeče na unutrašnjoj temperaturi od 69 stepeni Celzijusa kako bi se eliminisali bilo kakvi patogeni.
Kad su u pitanju odresci, oni su obično manje opasni jer se spoljne bakterije ubiju tokom procesa pečenja.
Unapred oprano i unapred skuvano voće i povrće
„Kad jedete hamburger, najopasniji deo nije sam burger. To su luk, zelena salata i paradajz", kaže Mansur Samadpur, savetnik za bezbednost hrane u TV seriji Otrovan.
Godine 2006. došlo je do masovne epidemije ešerihije koli povezane sa spanaćem - u SAD se razbolelo više od 200 ljudi a petoro ih je umrlo.
Marler je zastupao većinu žrtava.
Bakterijska kontaminacija na kraju je bila povezana sa farmom spanaća u Kaliforniji koja je imala životinjsku intruziju i fekalije su kontaminirale spanać ešerihijom koli.
Kad je bio isečen i poslat u pogon u kom se triput pere, ta bakterija bila je raširena među proizvodima i poslata u sve delove zemlje, otrovavši mnoge ljude.
„Da li je pogodnost što je neko oprao vašu zelenu salatu umesto vas vredna rizika da dođe u dodir sa više ljudi ? Ako dođe u dodir sa više ljudi i bude kontaminirana, ona se širi prilično brzo", kaže Marler.

Autor fotografije, Netflix
Sirova i nedovoljno kuvana jaja
Opasnost u jajima potiče od infekcije salmonelom, česte bakterije koja izaziva dijareju, temperaturu, povraćanje i stomačne grčeve.
Veoma mladi i veoma stari ljudi mogu ozbiljno da se razbole ili čak umru.
Bilo je mnogo katastrofalnih događaja sa jajima u skorašnjoj istoriji: godine 1988. bojazan od salmonele navela je britansku vladu da naredi pokolj više od dva miliona pilića.
Godine 2010, slična pretnja dovela je do povlačenja više od 500 miliona jaja u SAD.
Marler kaže da su jaja danas bezbednija nego što su bila ranije, ali poziva na oprez i veruje da salmonela i dalje predstavlja neprihvatljivi rizik za potrošače sirovih i nedovoljno kuvanih jaja.
„Svako 10.000. jaje ima salmonelu u ljusci. Kokoške mogu da imaju salmonelu u jajnicima - ona uđe u jaje i vi ne možete da uradite ništa drugo sem da ga dobro skuvate."
Sirove ostrige i druge sirove školjke
Rizik od ostriga i drugih sirovih školji je da se oni hrane sastojcima koji filtriraju u vodi.
To znači da ako u vodi postoji bakterijska ili virusna infekcija, ona će veoma lako ući u lanac ishrane.
A Marler smatra da problem dodatno pogoršava globalno zagrevanje.
„Sa zagrevanjem okeana dolazi i do porasta kontaminacija povezanih sa ostrigama: hepatiris, norovirus, itd.
„Ja sam iz Sijetla i neke od najboljih ostriga na svetu dolaze sa pacifičkog severozapada, ali očigledno postoje problemi sa kvalitetom naše vode i temperaturom.
„To je novi faktor rizika o kojem morate da da vodite računa kad naručujete sirove ostrige", kaže on.
Autor fotografije, Netflix
Upakovani sendviči
„Morate pažljivo da proveravate datume na sendvičima i po mogućstvu jedete hranu koju pripremate sami ili koja se priprema pred vama", savetuje Marler.
On upozorava da je starost sendviča veliki faktor rizika, koji bi mogao da dovede do izloženosti listeriji - veoma nezgodnoj bakteriji.
On kaže da je ona veliki ubica i u SAD i svuda u svetu, a skoro svake ko je unese u sebe završiće u bolnici.
„Listerija raste veoma dobro na frižiderskim temperaturama, tako da ako vam neko napravi sendvič i vi ga pojedete skoro odmah, rizik od listerioze je nizak.
„Ako ga naprave i pohrane u frižider na nedelju dana pre nego što ga pojedete, to će dati listeriji priliku da se dovoljno proširi da se razbolite", kaže on.
Ali suši je obično u redu
Ali jedna vrsta hrane povodom koje su ljudi redovno skeptični - suši - izaziva vrlo malo strahova kod Marlera, mada on priznaje da morate da budete oprezni gde da kupujete.
„Često ću pre otići u dobar suši restoran nego u restoran sa odrescima. Rizik od kontaminacije od ribe naprosto nije velik", kaže on.
„Ne kupujem suši u prodavnici ili na benzinskoj pumpi. Dobar suši restoran je prilično bezbedan jer ribe predstavljaju mali rizik kad je u pitanju bakterijska infekcija.
„To je profil rizika sa kojima sam prilično opušten", kaže on.

Pogledajte video:






























